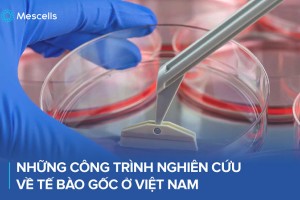

Hệ thống y tế chuyên sâu y học tái tạo và trị liệu tế bào Mescells | MSC
Mescells tự hào là đơn vị tiên phong tại Việt Nam sở hữu hệ sinh thái khép kín và chuyên sâu về công nghệ tế bào gốc. Với nền tảng pháp lý vững chắc và năng lực chuyên môn cao, Mescells đang từng bước khẳng định uy tín và vị thế hàng đầu trong lĩnh vực y học tái tạo.
Mô hình hệ sinh thái khép kín của Mescells bao gồm:
- Viện Nghiên cứu Ứng dụng Công nghệ Tế bào Mescells: Nghiên cứu, sản xuất tế bào gốc trung mô, thực hiện các đề tài khoa học chuyển giao công nghệ.
- Ngân hàng Mô Mescells: Chuyên lưu trữ mô mỡ, mô dây rốn.
- Hệ thống Phòng khám MSC: Chuyên ứng dụng Y học tái tạo trong Cơ xương khớp và Nội khoa.
- Trung tâm Đào tạo Mescells: Đào tạo, cấp chứng chỉ CME cho bác sĩ, nhân viên y tế về công nghệ tế bào gốc.
- Văn phòng Đại diện tại Nhật Bản: Kết nối khoa học công nghệ Việt Nam – Nhật Bản.
Lĩnh vực hoạt động
Nghiên cứu công nghệ tế bào
Nghiên cứu, sản xuất tế bào gốc trung mô, thực hiện các đề tài khoa học và chuyển giao công nghệ tế bào.
Ngân hàng Mô
Tiếp nhận, bảo quản, lưu trữ và vận chuyển mô mỡ, mô dây rốn đạt chuẩn quốc tế, phục vụ điều trị và nghiên cứu y học tái tạo.
Trung tâm đào tạo
Đào tạo cấp CME cho bác sĩ, nhân viên y tế về công nghệ tế bào gốc, góp phần nâng cao năng lực chuyên môn.
Khám phá hoạt động Mescells
Theo dõi thông tin mới tại đây
Báo chí nói về mescells
21/11/2025
Mescells ghi dấu ấn tại Lễ kỷ niệm 70 năm thành lập Cục Khoa học Công nghệ và Đào tạo – Bộ Y tế
Mới đây, báo Sức khỏe & Đời sống – cơ quan ngôn luận của Bộ Y tế – đã có bài viết ghi nhận những đóng góp nổi bật của Mescells tại Lễ kỷ niệm 70 năm thành lập Cục Khoa học Công nghệ và Đào tạo.
Đối tác của Mescells
Câu hỏi thường gặp
Mescells hoạt động trong lĩnh vực nào?
Hệ thống phòng LAB của Mescells có đạt tiêu chuẩn quốc tế không?
Ngân hàng Mô Mescells có chức năng gì?
Mescells có tham gia vào hoạt động đào tạo không?
Học viên có được nhận chứng chỉ sau khóa học không?
Công nghệ và quy trình sản xuất tế bào gốc tại Mescells có gì đặc biệt?